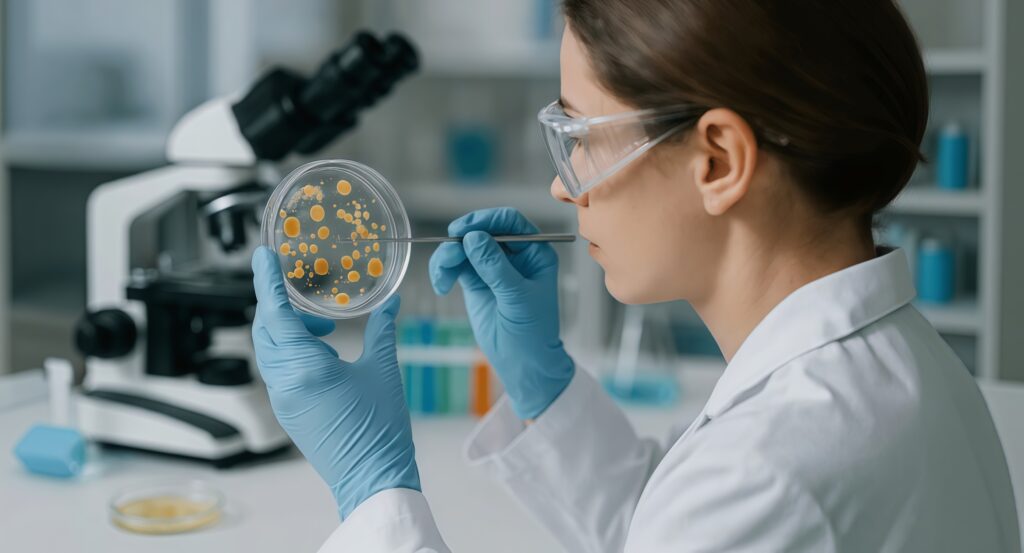

Содержание программы:
Обучение по программе микробиология даёт студентам понимание живого мира; знакомит с невидимыми человеческому глазу микробными процессами и организмами, оказывающими влияние на жизнь на нашей планете. Программа предоставляет базовые знания в различных областях естественных наук (математика, химия, статистика, биофизика, биохимия, молекулярная и клеточная биология, биоинформатика) и специальные знания по микробной физиологии, генетике, таксономии, биотехнологии, экологии, вирусологии, иммунологии и важности микробов в медицине.